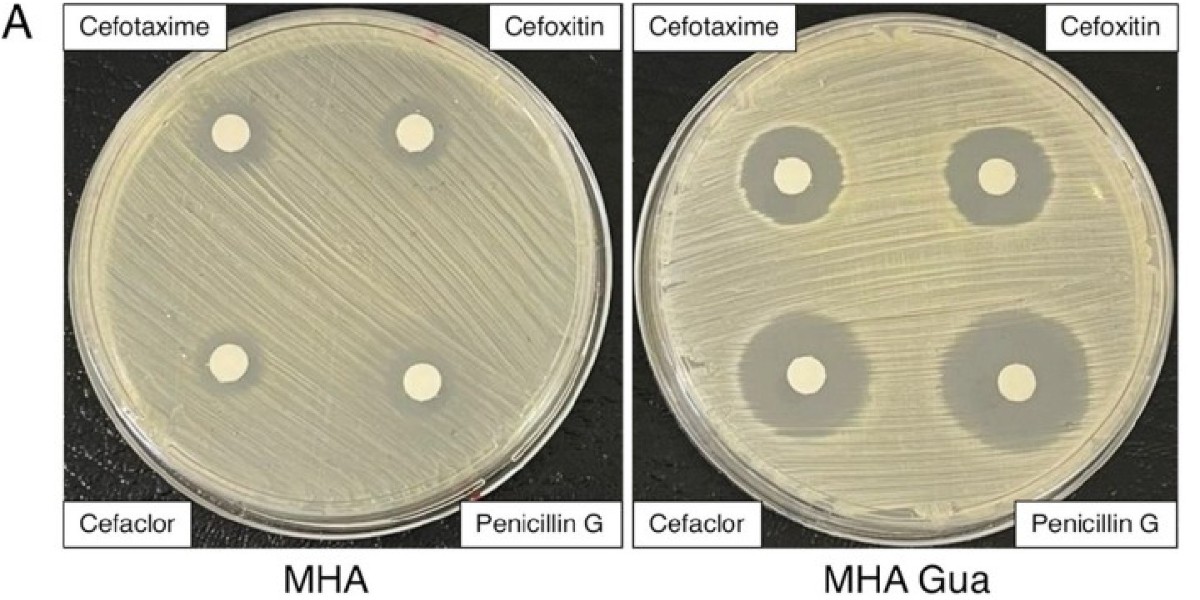
ASM tweet media

Arden retweetledi

#MicrobiologyMonday: Researchers found that the purine nucleosides, guanosine and xanthosine, act as adjuvants to re-sensitize methicillin-resistant Staphylococcus aureus (#MRSA) to oxacillin and other β-lactam antibiotics. Learn more in @mbiojournal: asm.social/XS
English






















